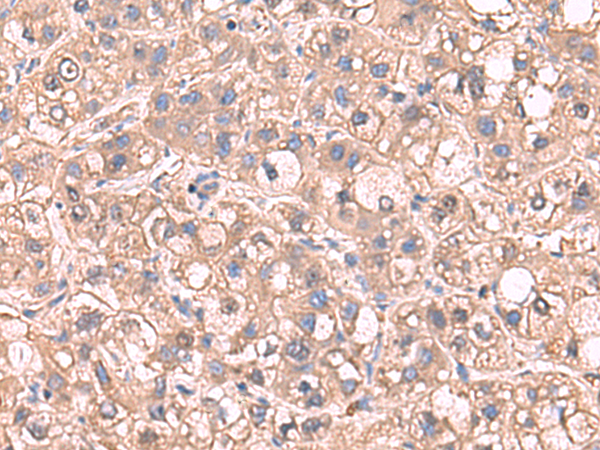

-
分类: 科研抗体货号: P10196别名: RIO1; AD034; RRP10; bA288G3.1应用: IHC反应种属: Human, Mouse
-
分类: 科研抗体货号: P10178别名:应用: WB,IHC反应种属: Human, Mouse, Rat
-
分类: 科研抗体货号: P10189别名: CDC20A; p55CDC; bA276H19.3应用: IHC反应种属: Human, Mouse, Rat
-
分类: 科研抗体货号: P10194别名: CCTE; HEL-S-69; PNAS-102; CCT-epsilon; TCP-1-epsilon应用: IHC反应种属: Human, Mouse, Rat
-
分类: 科研抗体货号: P10177别名: dJ20N2.5应用: WB,IHC反应种属: Human, Mouse, Rat
-
分类: 科研抗体货号: P10188别名: MFM3; TTID; TTOD; LGMD1; LGMD1A应用: WB,IHC反应种属: Human, Mouse
-
分类: 科研抗体货号: P10193别名: QIP2; RCH1; IPOA1; SRP1alpha; SRP1-alpha应用: WB,IHC反应种属: Human, Mouse
-
分类: 科研抗体货号: P10176别名: MRG1; PEMP; AAG12; EMP55; DXS552E应用: IHC反应种属: Human, Mouse
-
分类: 科研抗体货号: P10187别名: ARI2; TRIAD1应用: WB,IHC反应种属: Human, Mouse
-
分类: 科研抗体货号: P10192别名: SARS; SERS; SERRS; NEDMAS应用: WB,IHC反应种属: Human, Mouse, Rat

鄂公网安备42018502007531号
鄂公网安备42018502007531号

